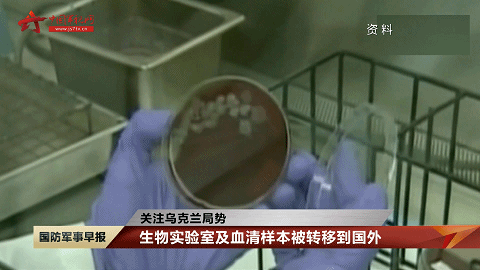

继本月11号,俄美驻联合国代表就在乌克兰发现美国资助的军事生物实验室问题激烈交锋后,俄驻美大使和美国务院发言人再次发声。
俄驻美大使:乌激进分子可能使用有毒化学试剂
近日,美国务院发言人普赖斯称,俄罗斯可能在乌克兰使用化学武器。对此,俄驻美大使安东诺夫驳斥,美方发表的言论毫无依据。
据塔斯社报道,俄驻美大使安东诺夫指出,俄罗斯在近日公布的文件中详细描述了乌克兰激进分子可能使用有毒化学试剂的情况,而这些行为是在美国情报机构代表的控制下策划的。
安东诺夫还说,与美国不同的是,俄罗斯2017年就销毁了所有军用毒剂储备,这在禁止化学武器组织得到书面证实。
乌美共建生物实验室
从事生物病毒研究
有数据显示,2005年以来,美国共在乌克兰建立了15个生物实验室,主要从事生物病毒研究,这些实验室多存泄漏劣迹,且被指曾于2017年秘密采集4400名乌克兰士兵血液进行疑似生物实验。

近日,新华社卫星新闻实验室定位了12座生物实验室,卫星图片显示,这些实验室位于哈尔科夫、利沃夫、基辅等地,且大多数实验室都位于城市社区之中。

生物实验室及血清样本
被转移到国外
俄罗斯方面表示,俄方发起特别军事行动后,有140多个装有蝙蝠体外寄生虫——跳蚤和蜱虫的容器从哈尔科夫的生物实验室转移到国外,还有大量来自乌克兰各地区、完全属于斯拉夫族群的血清样本被转移到国外。
另外,根据俄国防部日前公布的资料,R-781项目值得关注,该项目考虑将蝙蝠作为潜在生物武器制剂的载体。该项目包括研究能够从蝙蝠传播给人类的细菌和病毒病原体,包括鼠疫、钩端螺旋体病和冠状病毒等,这些研究是在紧邻俄边境的黑海沿岸和高加索地区进行的。

早在2020年初,世界卫生组织发布的最新疫情报告就指出,越来越多的证据表明,新冠病毒与其他已知在蝙蝠中传播的冠状病毒存在关联。
美或制造
针对各族裔群体的生物制剂
俄罗斯国防部近日指出,美国及其盟友的任务之一极有可能是制造能够有选择地针对各族裔群体的生物制剂。